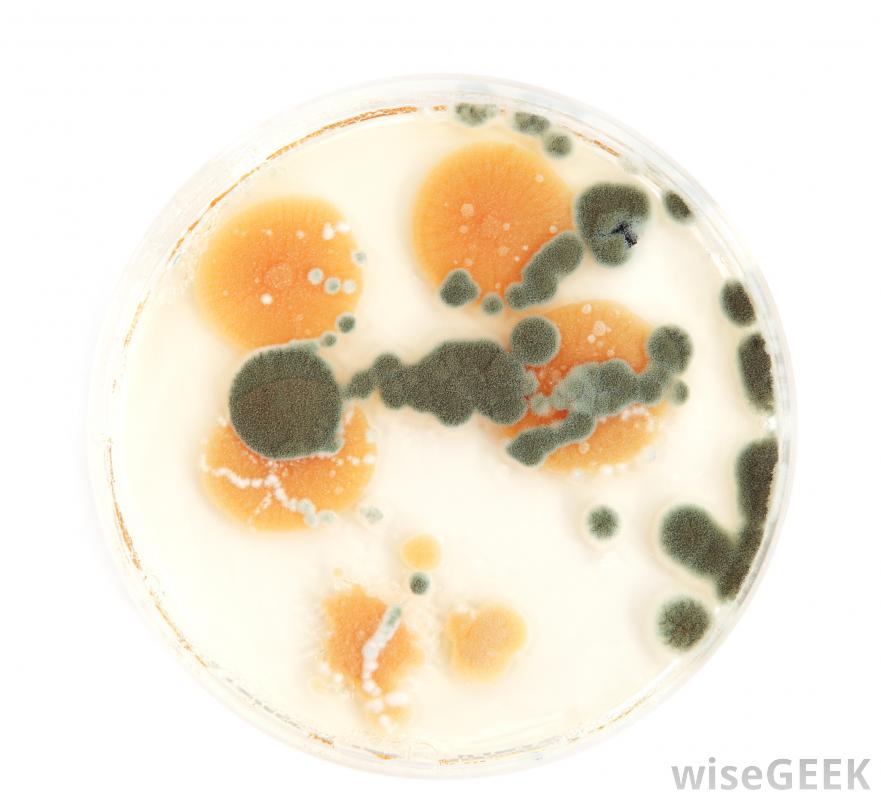

绿色霉菌是一个总括性术语,指的是孢子呈绿色的许多种真菌。更常见的种类通常属于三个属的真菌: 枝孢菌 , 曲霉 和青霉 。绿色霉菌在人们经常光顾的地区传播会对健康造成危害,就像其他霉菌变种一样,如果霉菌能渗透到家庭和...
绿色霉菌是一个总括性术语,指的是孢子呈绿色的许多种真菌。更常见的种类通常属于三个属的真菌:
枝孢菌,
曲霉和青霉。绿色霉菌在人们经常光顾的地区传播会对健康造成危害,就像其他霉菌变种一样,如果霉菌能渗透到家庭和隐蔽空间,有些霉菌与人接触时是相对良性的,而另一些种类的霉菌会引起更严重的健康问题,从感染到极度过敏反应和中毒
产生铅笔的霉菌是一种有用的绿色霉菌。更广泛地说,霉菌是一种微小的真菌,它们在环境中的许多不同表面上生存产生可以渗透到几乎任何空间的微小孢子,在合适的条件下从那里繁殖和传播。这些孢子决定了特定霉菌种的颜色。并非所有分类为枝孢菌的真菌,
曲霉或青霉将表现为绿色阴影,因为不同物种的颜色和作用范围不同。

绿色霉菌是食物变质的常见原因枝孢菌属真菌是一种非常常见的霉菌,在封闭的区域和室外都能找到,如果枝孢菌进入一个家庭,它通常会出现在墙壁、绝缘材料和木框架等表面,但大多位于容易潮湿的区域。与枝孢菌有关的健康问题通常与它的过敏特性有关孢子的存在会引发哮喘或呼吸系统疾病的症状,属于曲霉属的种类也会产生常见的绿色霉菌,这些绿色霉菌更喜欢高氧环境和是食物变质的一个常见原因。它们喜欢在面包和其他含淀粉的食物上生长,但它们也有能力在营养不足或完全缺乏的地区生长,例如被称为霉菌的曲霉曲霉会在室内传播,特别是在潮湿的地区,对人的健康构成严重威胁,黄曲霉(Aspergillus flavus)是一种具有致病性的有毒霉菌种,它能产生一种高致癌性的特异性毒素alflatoxin
青霉属(Penicillium)是一种著名的抗生素青霉素,它是一种具有医学价值的化合物,可以消除一些细菌感染。青霉属的孢子是最常见的绿色霉菌种,它们喜欢凉爽、温和的环境,如土壤。如曲霉菌,青霉属的绿霉菌也会污染食物供应,有些种类的青霉能产生非常有益的青霉素,而另一些种类则会释放真菌毒素,即真菌特有的毒素,这种毒素的作用会对暴露造成严重危害。